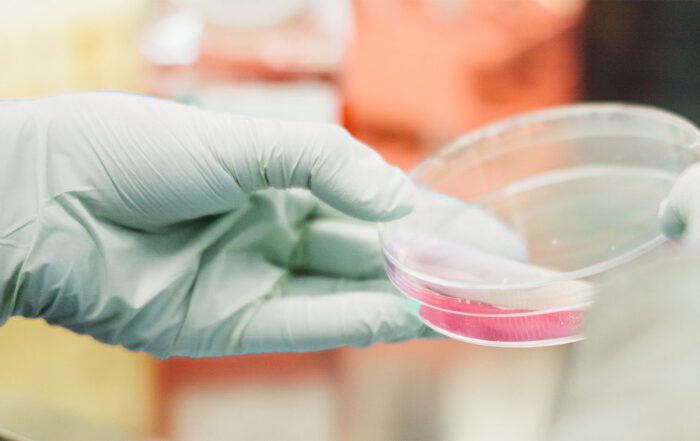

PROSENSO™
BIODEGRADABLE
ACCELERATOR-FREE
FOR MAXIMUM SKIN PROTECTION!
PROSENSO™ BIODEGRADABLE is the first ACCELERATOR-FREE biodegradable nitrile glove product on the market. The gloves are softer and more flexible than regular nitrile gloves and offer maximum protection for sensitive skin.

Selected clients from different sectors
Welcome to Eastwest Medico
Your specialized partner for premium quality Medical Gloves
As a family-owned company based in Copenhagen, Denmark, we specialize in manufacturing Examination Gloves made from Nitrile and Latex rubber. Our Prosenso™ brand encompasses various medical gloves, including aloe vera-coated, biodegradable, and powdered/powder-free versions. Along with our range of examination gloves, we are also an official distributor of Surgical Gloves from WRP, a market leader within its field. We demonstrate our commitment to upholding the highest quality standards with ISO 9001, ISO 13485, and ISO 14001 certifications. Rest assured, our gloves are approved by the European authorities and FDA, ensuring their safety and efficacy.
Committed to ethical trading, we work closely with the Danish Initiative for Ethical Trade (DIEH) and UN Global Compact to promote responsible sourcing. We prioritize meticulous quality control, conducting rigorous inspections and tests through our own dedicated team in Asia. Additionally, trusted third-party evaluation agencies like SGS and TÜV further verify the quality of our gloves, providing you with peace of mind. Discover the certified excellence of PROSENSO™ gloves trusted by medical professionals.
Read our articles about the EN455 standard
Our Carbon Reduction Plan
At Eastwest Medico, we are committed to addressing climate change and reducing our greenhouse gas (GHG) emissions. This nine-step Carbon Reduction Plan outlines our strategic approach and targets for mitigating our carbon footprint across our operations and value chain. By setting clear goals, implementing mitigation measures, and tracking our progress, we aim to contribute to a sustainable future and demonstrate our commitment to responsible business practices. Together, we can make a significant impact in reducing emissions and fostering a greener future.
Read our recent posts
How Are Nitrile Gloves Made? The Manufacturing Process Explained
Nitrile gloves are multi-purpose chemical-resistant gloves made from synthetic rubber and oils. Nitrile is a type of rubber known for its many use cases. But how do you make nitrile gloves? Let's take a
7 Uses for Latex Gloves: Cleaning, Gardening, and More
Disclaimer: Some people are allergic to Natural Rubber Latex. Only use latex gloves if you are confident you are not allergic to Natural Rubber Latex. All the tasks below can also be carried out
The History of Nitrile Gloves: A Vital Source of Protection
If you work in a factory, laboratory, or healthcare setting, you know how important it is to use the right gear for the job. There are numerous hazards that workers face every day, ranging
The Difference Between Nitrile, Latex and Vinyl Gloves
The best gloves to protect your hands from excessive water exposure, harsh chemicals, or other workplace dangers will vary by industry. The right gloves can also make it easier for you to do your
TAKE A LOOK AT OUR FOOD SAFE GLOVES
High volume and fast delivery of all products in stock
Introducing PROSENSO™ BLACK, the ultimate choice for food safety. These gloves are specifically designed and certified to meet the highest standards of hygiene when handling food. With PROSENSO™ BLACK, you can confidently protect your hands and maintain the integrity of the food you handle. Elevate your culinary experience with PROSENSO™ BLACK gloves and ensure impeccable food safety every time.
HAVE YOU HEARD ABOUT BIODEGRADABLE NITRILE GLOVES?
A new revolution
PROSENSO™ BIODEGRADABLE is a breakthrough in hand protection. These nitrile gloves are biodegradable and accelerator-free, reducing their environmental impact. With a unique NBR formula, they naturally break down within 3-5 years, making them a sustainable choice without compromising on quality or performance. Choose PROSENSO™ BIODEGRADABLE for a greener future.